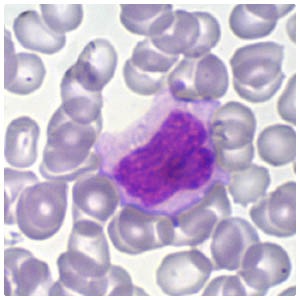

Monócitos


Núcleo irregular apresentando cromatina delicada. Citoplasma abundante com alguns vacúolos.

Núcleo irregular apresentando cromatina delicada. Citoplasma moderado com regiões mais basofílicas na periferia exibindo uma discreta granulação.

Núcleo bastante irregular com cromatina delicada. Citoplasma moderado com coloração avermelhada.

Núcleo irregular apresentando cromatina mais condensada. Citoplasma moderado com regiões mais basofílicas na periferia. Alguns vacúolos citoplasmáticos.

Núcleo irregular apresentando vacúolos. Citoplasma moderado, azul claro bem vacuolizado.
Núcleo irregular apresentando cromatina sem grande condensação. Citoplasma moderado com regiões mais basofílicas na periferia.




Nenhum comentário:
Postar um comentário